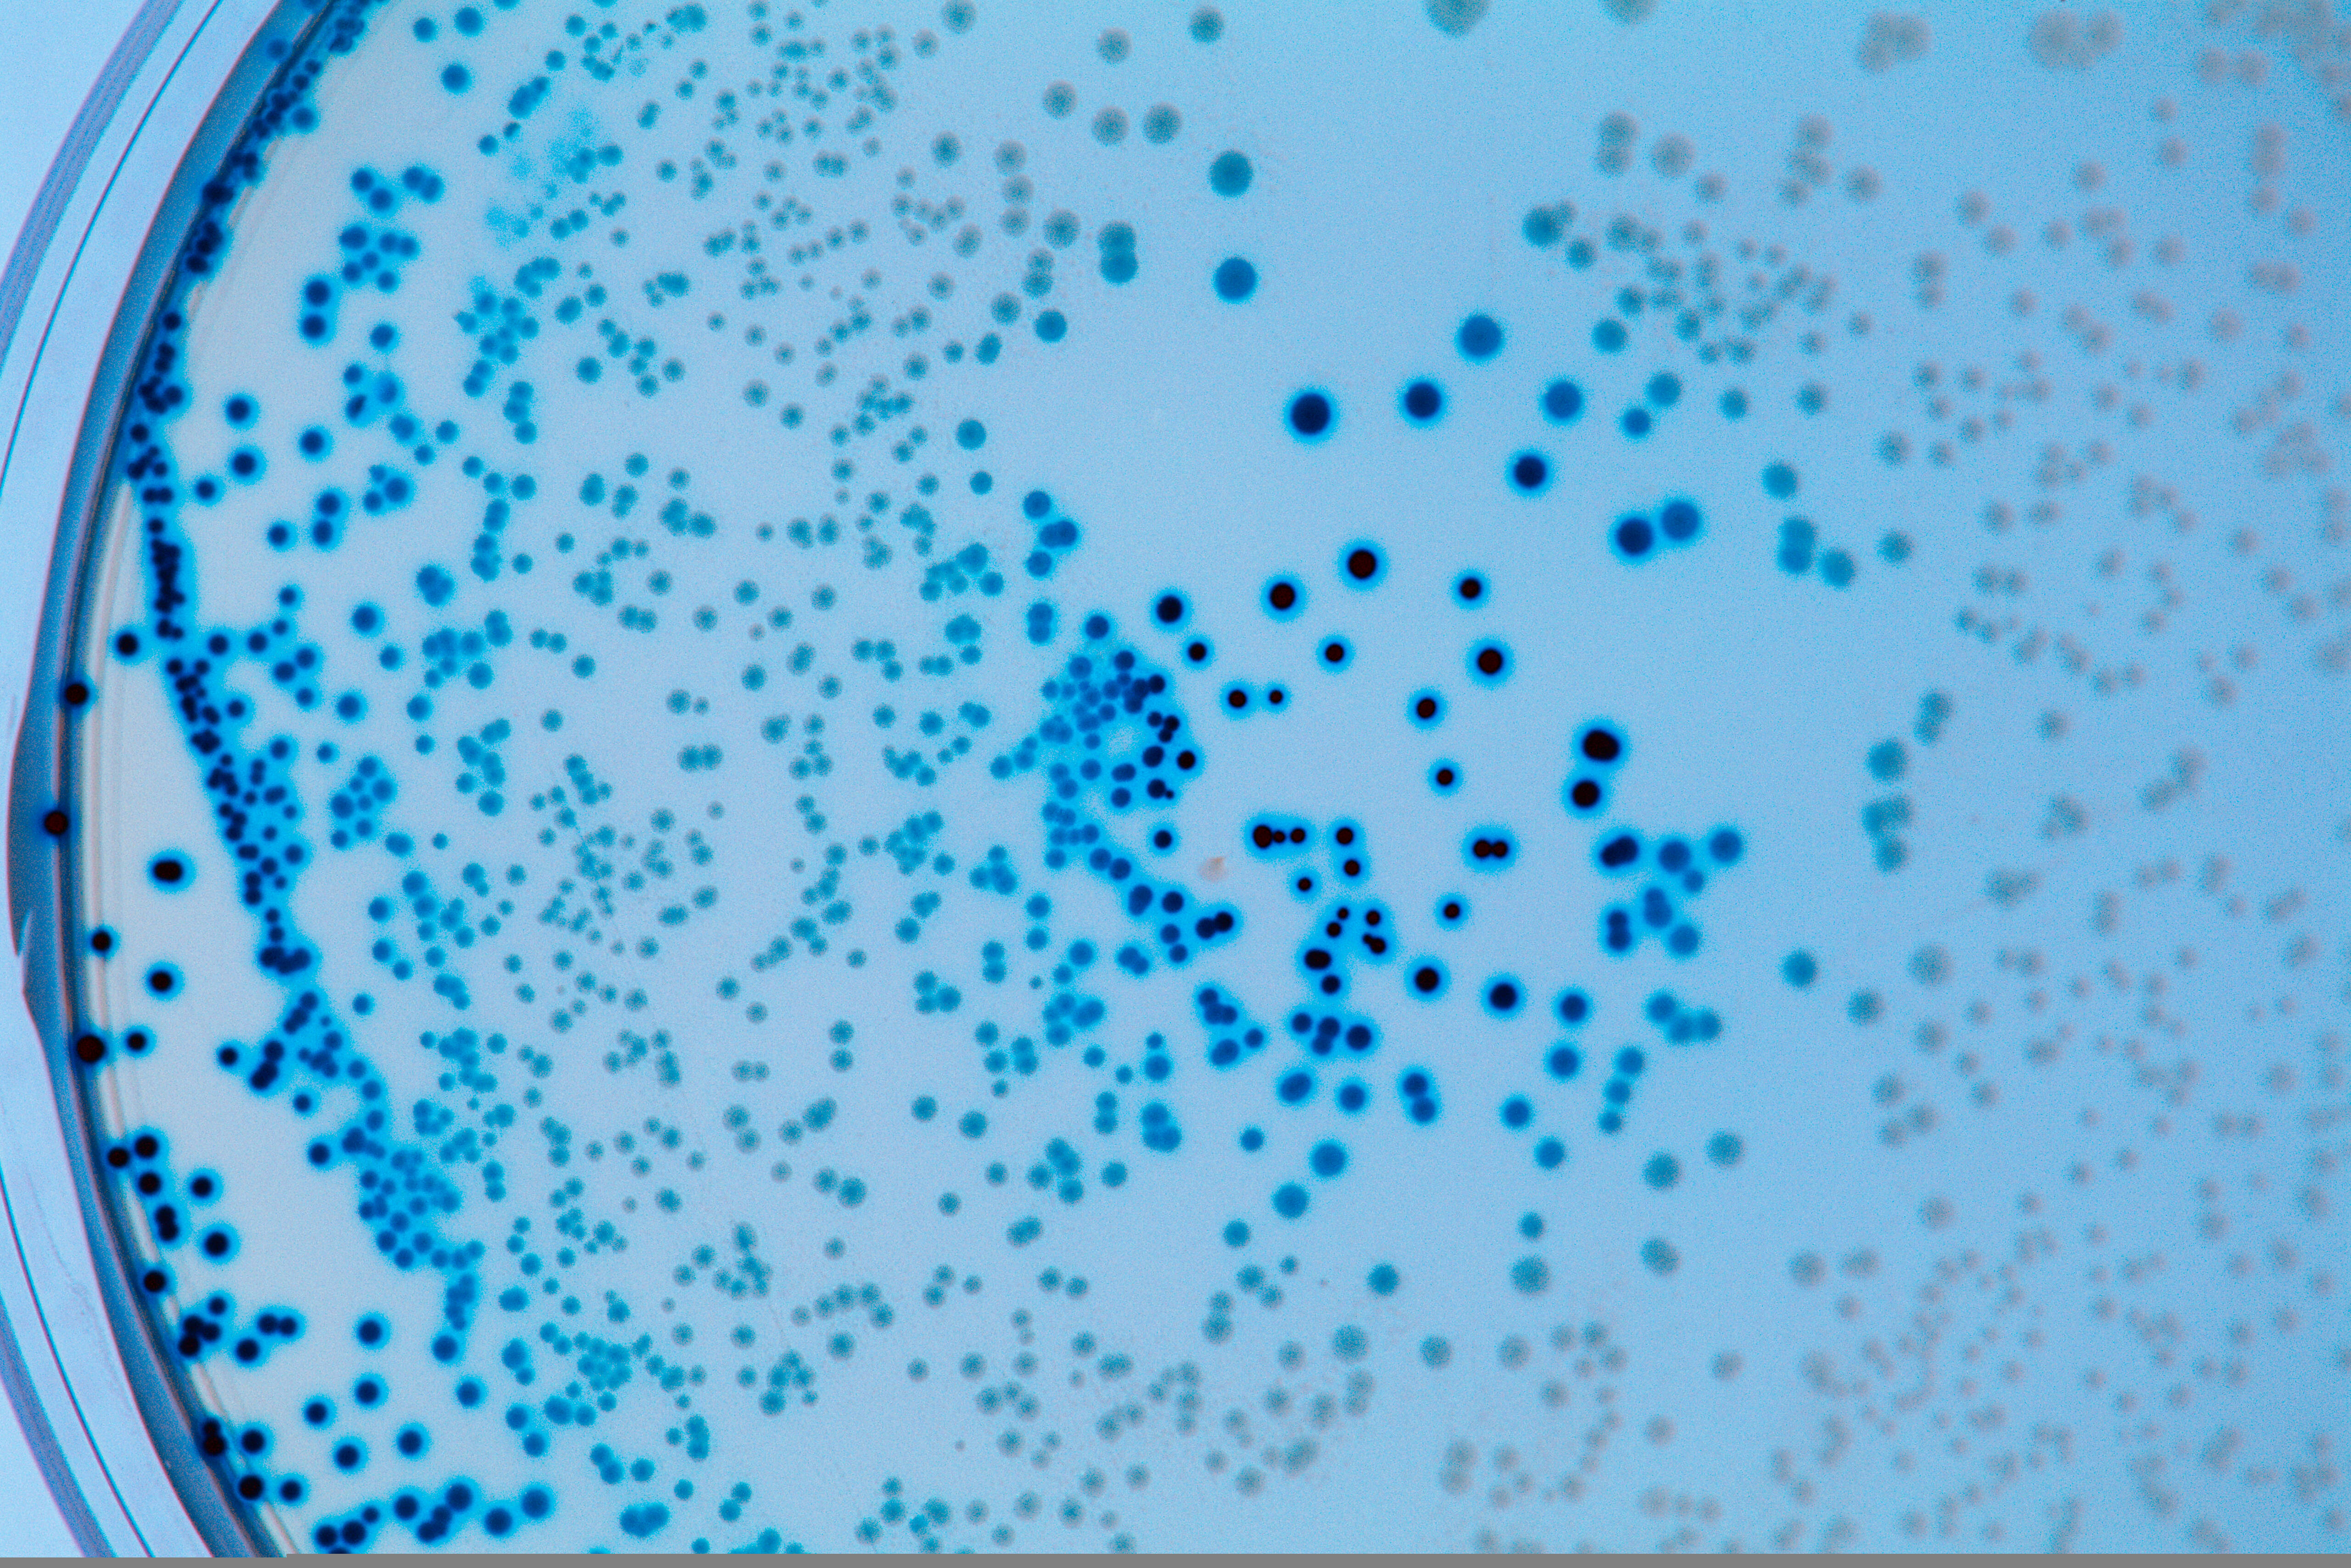

Уксусные бактерии
Можно ли отправить велосипед сдэком
Стейки на решетке в фольге
Хочу на ручки маме
Артоксан или диклофенак
Получен заем по договору займа проводка
Заклинило кофемашина делонги
Футбол клуб барселона
Мориц язык
Интеллектуальная игра для детей мероприятие
Аккл матизация
Какие звуки являются звонкими парными
Тема оды ломоносова вечернее размышление
Конспект по теме экология
Уксусные бактерии 113 фотографий